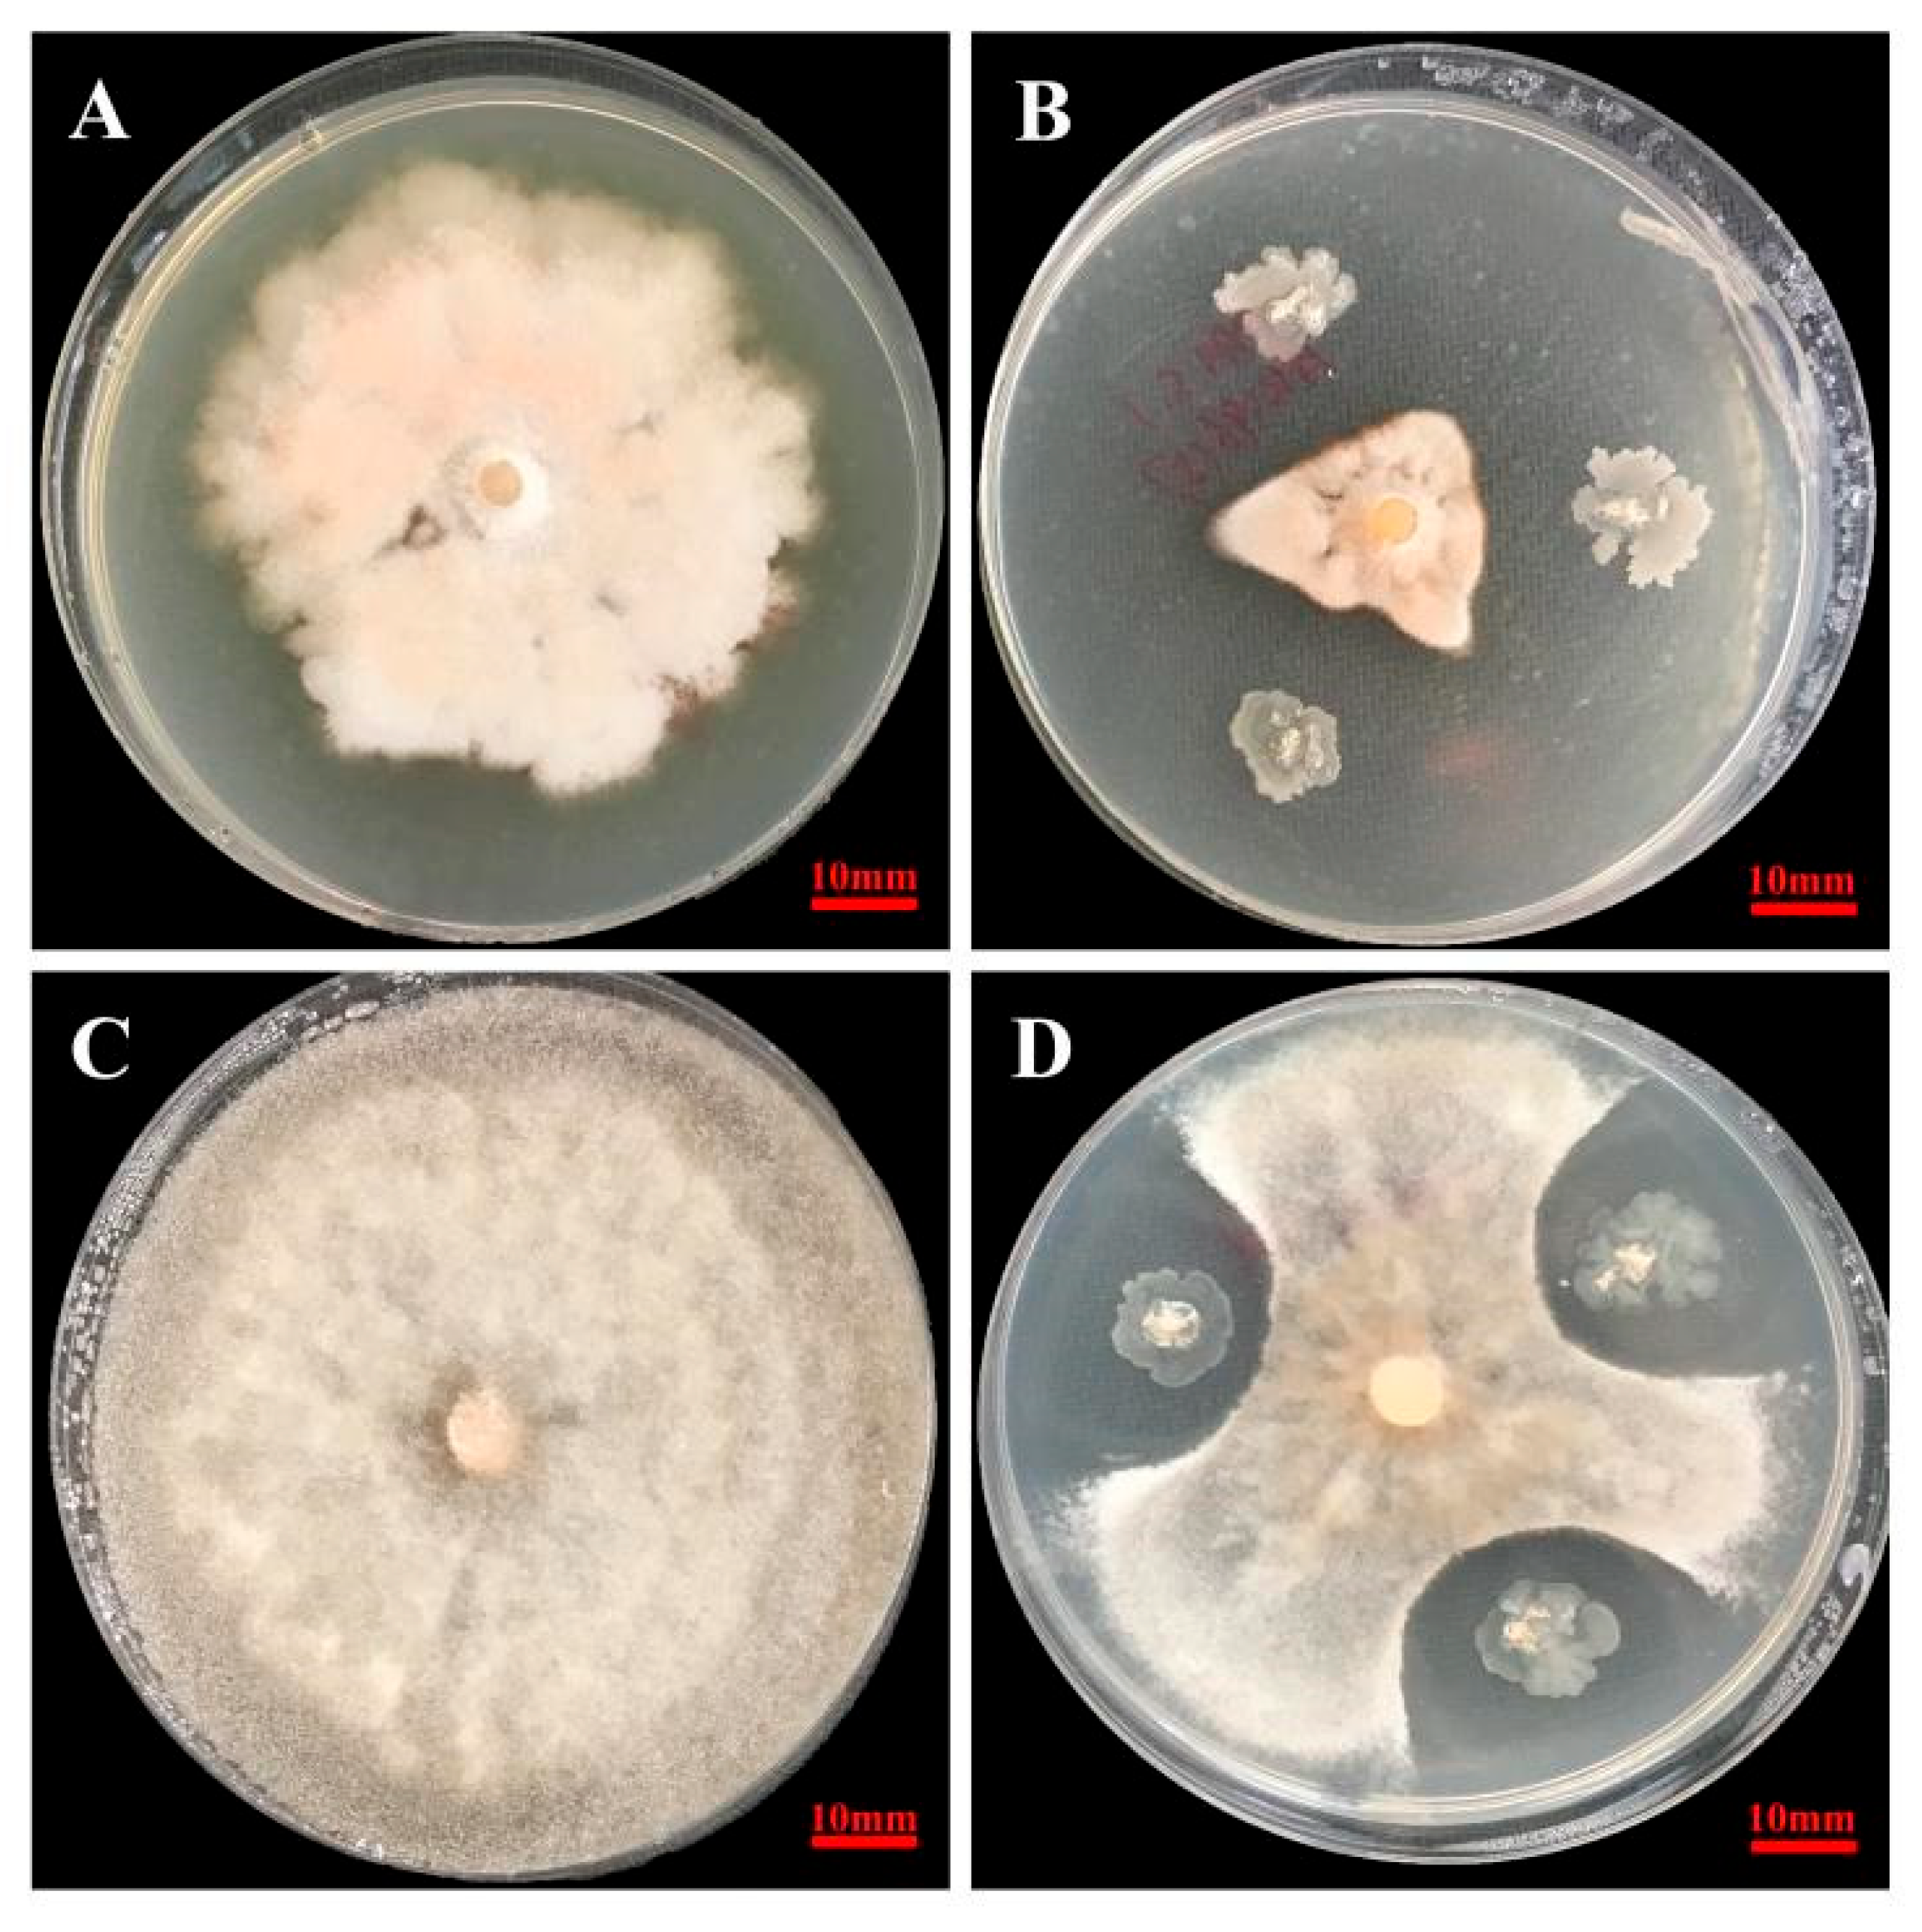
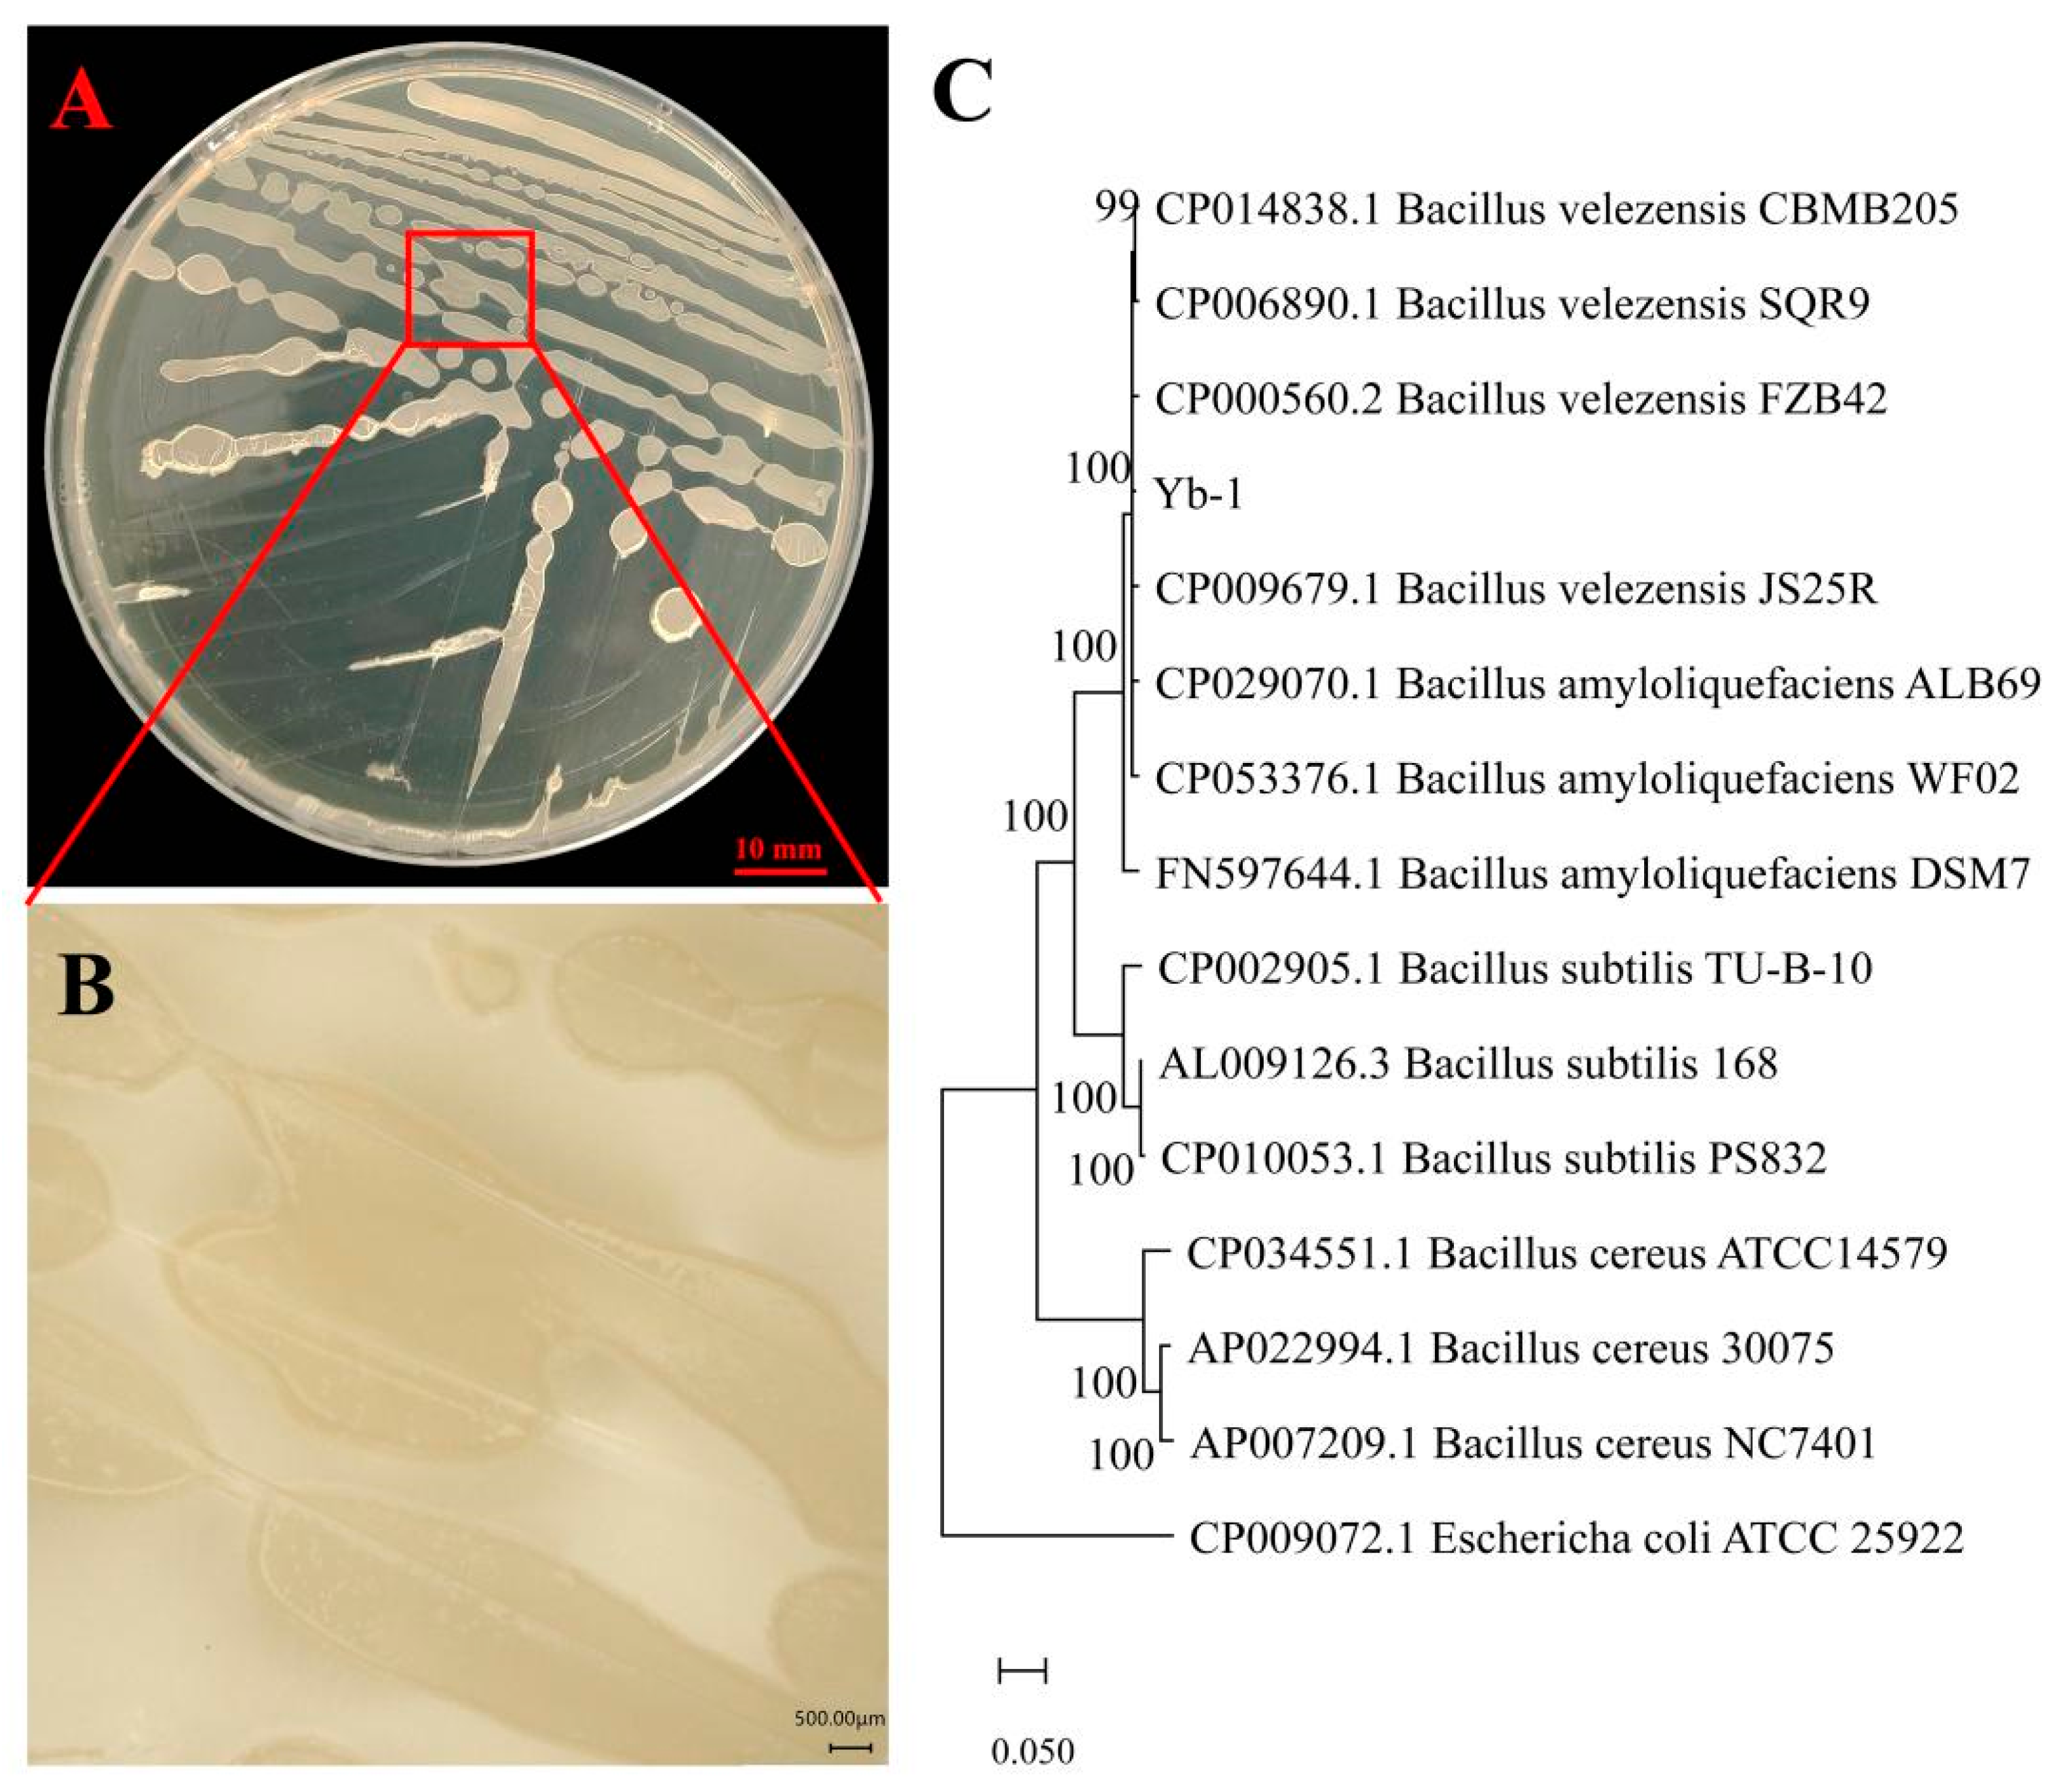

Identification, Biocontrol Activity, and Field Application Effect of Bacillus velezensis Yb-1
Abstract
1. Introduction
2. Materials and Methods
2.1. Microorganisms and Growth Condition
2.2. Determination of Antifungal Activity
2.3. Identification of Yb-1
2.4. The Growth-Promotion Ability of Yb-1 in Pepper Seedlings
2.5. Safety Evaluation of Yb-1 to Pepper
2.6. Field Efficacy Assessment of Strain Yb-1 against Pepper Anthracnose
2.6.1. Field Experiment Design
2.6.2. Methods of Investigation
2.7. Statistical Analysis
3. Results
3.1. Antagonistic Activity of Yb-1
3.2. Identification of Yb-1
3.3. Effect of Yb-1 on the Germination and Growth of Pepper Seeds
3.4. Safety Evaluation of Yb-1 to Peppers
3.5. Evaluation of the Biocontrol of Pepper Anthracnose with Strain Yb-1 in the Field
4. Discussion
Author Contributions
Funding
Data Availability Statement
Conflicts of Interest
References
- Ali, A.; Bordoh, P.K.; Singh, A.; Siddiqui, Y.; Droby, S. Post-harvest development of anthracnose in pepper (Capsicum spp.): Etiology and management strategies. Crop Prot. 2016, 90, 132–141. [Google Scholar] [CrossRef]
- Zou, Z.; Zou, X. Geographical and Ecological Differences in Pepper Cultivation and Consumption in China. Front. Nutr. 2021, 8, 718517. [Google Scholar] [CrossRef] [PubMed]
- Droby, S.; Wisniewski, M.; Teixidó, N.; Spadaro, D.; Jijakli, M.H. The science, development, and commercialization of postharvest biocontrol products. Postharvest Biol. Technol. 2016, 122, 22–29. [Google Scholar] [CrossRef]
- Shafi, J.; Tian, H.; Ji, M. Bacillus species as versatile weapons for plant pathogens: A review. Biotechnol. Biotec. Equip. 2017, 31, 446–459. [Google Scholar] [CrossRef]
- Carmona-Hernandez, S.; Reyes-Pérez, J.; Chiquito-Contreras, R.; Rincon-Enriquez, G.; Cerdan-Cabrera, C.; Hernandez-Montiel, L. Biocontrol of Postharvest Fruit Fungal Diseases by Bacterial Antagonists: A Review. Agronomy 2019, 9, 121. [Google Scholar] [CrossRef]
- Freimoser, F.M.; Rueda-Mejia, M.P.; Tilocca, B.; Migheli, Q. Biocontrol yeasts: Mechanisms and applications. World J. Microbiol. Biotechnol. 2019, 35, 154. [Google Scholar] [CrossRef]
- De Lamo, F.J.; Takken, F.L.W. Biocontrol by Fusarium oxysporum Using Endophyte-Mediated Resistance. Front. Plant Sci. 2020, 11, 37. [Google Scholar] [CrossRef]
- Fira, D.; Dimkic, I.; Beric, T.; Lozo, J.; Stankovic, S. Biological control of plant pathogens by Bacillus species. J. Biotechnol. 2018, 285, 44–55. [Google Scholar] [CrossRef]
- Chen, K.; Tian, Z.; He, H.; Long, C.-a.; Jiang, F. Bacillus species as potential biocontrol agents against citrus diseases. Biol. Control 2020, 151, 104419. [Google Scholar] [CrossRef]
- Cui, L.; Yang, C.; Wei, L.; Li, T.; Chen, X. Isolation and identification of an endophytic bacteria Bacillus velezensis 8-4 exhibiting biocontrol activity against potato scab. Biol. Control 2020, 141, 104156. [Google Scholar] [CrossRef]
- Blake, C.; Christensen, M.N.; Kovacs, A.T. Molecular Aspects of Plant Growth Promotion and Protection by Bacillus subtilis. Mol. Plant Microbe Interact. 2021, 34, 15–25. [Google Scholar] [CrossRef]
- Sun, B.; Gu, L.; Bao, L.; Zhang, S.; Wei, Y.; Bai, Z.; Zhuang, G.; Zhuang, X. Application of biofertilizer containing Bacillus subtilis reduced the nitrogen loss in agricultural soil. Soil Biol. Biochem. 2020, 148, 107911. [Google Scholar] [CrossRef]
- Prakash, J.; Arora, N.K. Phosphate-solubilizing Bacillus sp. enhances growth, phosphorus uptake and oil yield of Mentha arvensis L. 3 Biotech 2019, 9, 126. [Google Scholar] [CrossRef]
- Miljakovic, D.; Marinkovic, J.; Balesevic-Tubic, S. The Significance of Bacillus spp. in Disease Suppression and Growth Promotion of Field and Vegetable Crops. Microorganisms 2020, 8, 1037. [Google Scholar] [CrossRef]
- Nie, P.; Li, X.; Wang, S.; Guo, J.; Zhao, H.; Niu, D. Induced Systemic Resistance against Botrytis cinerea by Bacillus cereus AR156 through a JA/ET- and NPR1-Dependent Signaling Pathway and Activates PAMP-Triggered Immunity in Arabidopsis. Front. Plant Sci. 2017, 8, 238. [Google Scholar] [CrossRef]
- Kildea, S.; Ransbotyn, V.; Khan, M.R.; Fagan, B.; Leonard, G.; Mullins, E.; Doohan, F.M. Bacillus megaterium shows potential for the biocontrol of septoria tritici blotch of wheat. Biol. Control 2008, 47, 37–45. [Google Scholar] [CrossRef]
- Gond, S.K.; Bergen, M.S.; Torres, M.S.; White, J.F., Jr. Endophytic Bacillus spp. produce antifungal lipopeptides and induce host defence gene expression in maize. Microbiol. Res. 2015, 172, 79–87. [Google Scholar] [CrossRef]
- Jayapala, N.; Mallikarjunaiah, N.H.; Puttaswamy, H.; Gavirangappa, H.; Ramachandrappa, N.S. Rhizobacteria Bacillus spp. induce resistance against anthracnose disease in chili (Capsicum annuum L.) through activating host defense response. Egypt. J. Biol. Pest Control 2019, 29, 45. [Google Scholar] [CrossRef]
- Marquez, R.; Blanco, E.L.; Aranguren, Y. Bacillus strain selection with plant growth-promoting mechanisms as potential elicitors of systemic resistance to gray mold in pepper plants. Saudi J. Biol. Sci. 2020, 27, 1913–1922. [Google Scholar] [CrossRef]
- Zheng, T.-w.; Liu, L.; Nie, Q.-w.; Hsiang, T.; Sun, Z.-x.; Zhou, Y. Isolation, identification and biocontrol mechanisms of endophytic bacterium D61-A from Fraxinus hupehensis against Rhizoctonia solani. Biol. Control 2021, 158, 104621. [Google Scholar] [CrossRef]
- Khan, M.S.; Gao, J.; Chen, X.; Zhang, M.; Yang, F.; Du, Y.; Moe, T.S.; Munir, I.; Xue, J.; Zhang, X. Isolation and Characterization of Plant Growth-Promoting Endophytic Bacteria Paenibacillus polymyxa SK1 from Lilium lancifolium. BioMed Res. Int. 2020, 2020, 8650957. [Google Scholar] [CrossRef] [PubMed]
- Dong, X.Z.; Cai, M.Y. Manual of Identification of Common Bacterial Systems; Science Press: Beijing, China, 2001. [Google Scholar]
- Dees, P.M.; Ghiorse, W.C. Microbial diversity in hot synthetic compost as revealed by PCR-amplified rRNA sequences from cultivated isolates and extracted DNA. FEMS Microbiol. Ecol. 2001, 35, 207–216. [Google Scholar] [CrossRef] [PubMed]
- Chun, J.; Bae, K.S. Phylogenetic analysis of Bacillus subtilis and related taxa based on partial gyrA gene sequences. Antonie Van Leeuwenhoek J. Microbiol. Serol. 2000, 2, 78. [Google Scholar]
- Kenichi, K.; Masao, F.; Ryuji, K. Detection and Identification of Escherichia coli, Shigella, and Salmonella by Microarrays Using the gyrB Gene. Biotechnol. Bioeng. 2003, 83, 721–728. [Google Scholar]
- Altschul, S.F.; Gish, W.; Miller, W.; Myers, E.W.; Lipman, D.J. Basic local alignment search tool. J. Mol. Biol. 1990, 215, 403–410. [Google Scholar] [CrossRef]
- Tamura, K.; Nei, M.; Kumar, S. Prospects for inferring very large phylogenies by using the neighbor-joining method. Proc. Natl. Acad. Sci. USA 2004, 101, 30. [Google Scholar] [CrossRef]
- Li, E.; Li, Y.; Dai, X.; Yan, W.; Wang, G. Identification of Two Bacillus Strains with Antimicrobial Activity and Preliminary Evaluation of Their Biocontrol Efficiency. Horticulturae 2022, 8, 744. [Google Scholar] [CrossRef]
- Wang, L.; Xi, N.; Lang, D.; Zhou, L.; Zhang, Y.; Zhang, X. Potential biocontrol and plant growth promotion of an endophytic bacteria isolated from Glycyrrhiza uralensis seeds. Egypt. J. Biol. Pest Control 2022, 3, 55. [Google Scholar] [CrossRef]
- GB/T 17980.33-2000; National Standards Pesticide-Guidelines for the Field Efficacy Trials (Ⅰ) Fungicides against Pepper Anthracnose. Ministry of Agriculture and Rural Affairs: Beijing, China, 2000.
- Panuwet, P.; Siriwong, W.; Prapamontol, T.; Ryan, P.B.; Fiedler, N.; Robson, M.G.; Barr, D.B. Agricultural Pesticide Management in Thailand: Situation and Population Health Risk. Environ. Sci. Policy 2012, 17, 72–81. [Google Scholar] [CrossRef]
- Donley, N. The USA lags behind other agricultural nations in banning harmful pesticides. Environ Health 2019, 18, 44. [Google Scholar] [CrossRef]
- Kristoffersen, P.; Rask, A.M.; Grundy, A.C.; Franzen, I.; Kempenaar, C.; Raisio, J.; Schroeder, H.; Spijker, J.; Verschwele, A.; Zarina, L. A review of pesticide policies and regulations for urban amenity areas in seven European countries. Weed Res. 2008, 48, 201–214. [Google Scholar] [CrossRef]
- Ibarra-Villarreal, A.L.; Gándara-Ledezma, A.; Godoy-Flores, A.D.; Herrera-Sepúlveda, A.; Díaz-Rodríguez, A.M.; Parra-Cota, F.I.; de los Santos-Villalobos, S. Salt-tolerant Bacillus species as a promising strategy to mitigate the salinity stress in wheat (Triticum turgidum subsp. durum). J. Arid Environ. 2021, 186, 104399. [Google Scholar] [CrossRef]
- Franco-Duarte, R.; Cernakova, L.; Kadam, S.; Kaushik, K.S.; Salehi, B.; Bevilacqua, A.; Corbo, M.R.; Antolak, H.; Dybka-Stepien, K.; Leszczewicz, M.; et al. Advances in Chemical and Biological Methods to Identify Microorganisms-From Past to Present. Microorganisms 2019, 7, 130. [Google Scholar] [CrossRef]
- Cabral, A.; Rego, C.; Nascimento, T.; Oliveira, H.; Groenewald, J.Z.; Crous, P.W. Multi-gene analysis and morphology reveal novel Ilyonectria species associated with black foot disease of grapevines. Fungal Biol. 2012, 116, 62–80. [Google Scholar] [CrossRef]
- Bakhshi, M.; Arzanlou, M.; Babai-Ahari, A.; Groenewald, J.Z.; Crous, P.W. Multi-gene analysis of Pseudocercospora spp. from Iran. Phytotaxa 2014, 184, 245. [Google Scholar] [CrossRef]
- Liu, Y.; Teng, K.; Wang, T.; Dong, E.; Zhang, M.; Tao, Y.; Zhong, J. Antimicrobial Bacillus velezensis HC6: Production of three kinds of lipopeptides and biocontrol potential in maize. J. Appl. Microbiol. 2020, 128, 242–254. [Google Scholar] [CrossRef]
- Meng, Q.; Jiang, H.; Hao, J.J. Effects of Bacillus velezensis strain BAC03 in promoting plant growth. Biol. Control 2016, 98, 18–26. [Google Scholar] [CrossRef]
- Jiang, C.H.; Yao, X.F.; Mi, D.D.; Li, Z.J.; Yang, B.Y.; Zheng, Y.; Qi, Y.J.; Guo, J.H. Comparative Transcriptome Analysis Reveals the Biocontrol Mechanism of Bacillus velezensis F21 Against Fusarium Wilt on Watermelon. Front. Microbiol. 2019, 10, 652. [Google Scholar] [CrossRef]
- Myo, E.M.; Liu, B.; Ma, J.; Shi, L.; Jiang, M.; Zhang, K.; Ge, B. Evaluation of Bacillus velezensis NKG-2 for bio-control activities against fungal diseases and potential plant growth promotion. Biol. Control 2019, 134, 23–31. [Google Scholar] [CrossRef]
- Zhang, X.; Zhou, Y.; Li, Y.; Fu, X.; Wang, Q. Screening and characterization of endophytic Bacillus for biocontrol of grapevine downy mildew. Crop Prot. 2017, 96, 173–179. [Google Scholar] [CrossRef]
- Jiang, C.-H.; Liao, M.-J.; Wang, H.-K.; Zheng, M.-Z.; Xu, J.-J.; Guo, J.-H. Bacillus velezensis, a potential and efficient biocontrol agent in control of pepper gray mold caused by Botrytis cinerea. Biol. Control 2018, 126, 147–157. [Google Scholar] [CrossRef]
- Ferraz, L.P.; Cunha, T.D.; da Silva, A.C.; Kupper, K.C. Biocontrol ability and putative mode of action of yeasts against Geotrichum citri-aurantii in citrus fruit. Microbiol. Res. 2016, 188–189, 72–79. [Google Scholar] [CrossRef] [PubMed]
- Yan, H.; Qiu, Y.; Yang, S.; Wang, Y.; Wang, K.; Jiang, L.; Wang, H. Antagonistic Activity of Bacillus velezensis SDTB038 against Phytophthora infestans in Potato. Plant Dis. 2021, 105, 1738–1747. [Google Scholar] [CrossRef] [PubMed]

| Yb-1 Suspension Treatment (CUF/mL) | |||||||
|---|---|---|---|---|---|---|---|
| CK | 103 | 104 | 105 | 106 | 107 | 108 | |
| Germination rate/% | 86.67 b | 85.00 b | 98.33 a | 96.66 a | 86.67 b | 83.33 b | 0.00 c |
| Treatment | Disease Index Before Treatment | Disease Index After Treatment | Control Effect/% |
|---|---|---|---|
| A | 0.96 a | 5.41 b | 59.45 c |
| B | 1.04 a | 5.11 b | 64.63 b |
| C | 0.89 a | 3.41 c | 71.98 a |
| D | 1.04 a | 13.34 a | / |
Disclaimer/Publisher’s Note: The statements, opinions and data contained in all publications are solely those of the individual author(s) and contributor(s) and not of MDPI and/or the editor(s). MDPI and/or the editor(s) disclaim responsibility for any injury to people or property resulting from any ideas, methods, instructions or products referred to in the content. |
© 2023 by the authors. Licensee MDPI, Basel, Switzerland. This article is an open access article distributed under the terms and conditions of the Creative Commons Attribution (CC BY) license (https://creativecommons.org/licenses/by/4.0/).
Share and Cite
Wang, B.; Li, E.; Lin, Y.; Xiao, T.; Ji, X.; Zhao, Z.; Yan, W. Identification, Biocontrol Activity, and Field Application Effect of Bacillus velezensis Yb-1. Horticulturae 2023, 9, 376. https://doi.org/10.3390/horticulturae9030376
Wang B, Li E, Lin Y, Xiao T, Ji X, Zhao Z, Yan W. Identification, Biocontrol Activity, and Field Application Effect of Bacillus velezensis Yb-1. Horticulturae. 2023; 9(3):376. https://doi.org/10.3390/horticulturae9030376
Chicago/Turabian StyleWang, Bao, Erfeng Li, Yang Lin, Tongbin Xiao, Xuncong Ji, Zhixiang Zhao, and Wanrong Yan. 2023. "Identification, Biocontrol Activity, and Field Application Effect of Bacillus velezensis Yb-1" Horticulturae 9, no. 3: 376. https://doi.org/10.3390/horticulturae9030376
APA StyleWang, B., Li, E., Lin, Y., Xiao, T., Ji, X., Zhao, Z., & Yan, W. (2023). Identification, Biocontrol Activity, and Field Application Effect of Bacillus velezensis Yb-1. Horticulturae, 9(3), 376. https://doi.org/10.3390/horticulturae9030376

